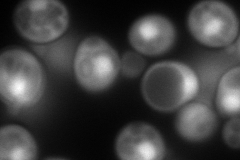
YGR087C
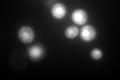
YGR087C

View description
Minor isoform of pyruvate decarboxylase, decarboxylates pyruvate to acetaldehyde, involved in amino acid catabolism; transcription is glucose- and ethanol-dependent, and is strongly induced during sulfur limitation
Localization:
Intensity:
Fold change:
Significance:
-
C’ GFP library in SD

nucleus28.24 -
N' NOP1pr-GFP in SD
nucleus328.632 -
N' TEF2pr-mCherry in SD

missing0 -
N' NATIVEpr-GFP in SD

missing0 -
N' TEF2pr-VC and Cyto-VN in SD

#N/A0 -
C’ GFP library in SD+DTT

nucleus44.051.55Yes -
C’ GFP library in SD+H2O2

nucleus63.512.24Yes -
C’ GFP library in Starvation Media
nucleus770.2227.27Yes -
C’ GFP library on the background of Pup2-DaMP

N/A -
C’ GFP library on the background of CCT mutant

N/A0N/AYes
